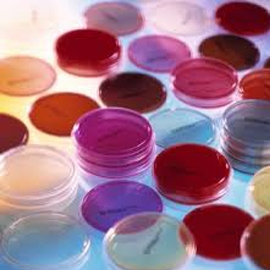

Yellow Cones & Blue Cones
Consommables plastiques

PCR
Consommables plastiques

Scales
Instruments de mesures

NGS sequencing
Services

thermoblock
Equipements de laboratoire

Latex glove
Sécurité et hygiène

Eppendorf tube 1.5 - 2 ml & 0.5ml
Consommables plastiques
90mm & 60mm Petri dish
Consommables plastiques